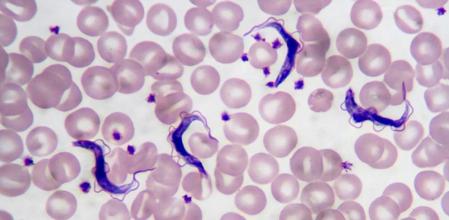
Horizontal

La enfermedad del sueño, también llamada tripanosomiasis africana (THA), está causada por dos parásitos protozoarios, el ‘Trypanosoma brucei rhodesiense’ y el ‘Trypanosoma brucei gambiense’ que penetran en el organismo humano por la picadura de la mosca tse-tsé. La enfermedad tiene varias fases de desarrollo, pero se caracteriza especialmente por producir un estado de somnolencia constante que acaba derivando en la muerte del paciente.
Causas de la enfermedad del sueño
Picadura de insecto
La causa de la enfermedad es la picadura de la mosca tse-tsé. Este insecto vive únicamente en el África subsahariana y suele suelen habitar en la vegetación de las zonas costeras, así como en ríos y lagos. Las moscas están infectadas al chupar la sangre de algún animal infectado. Pican de día y su picadura produce dolor.
Síntomas de la enfermedad del sueño
Aparecen una semana después de la picadura
Los primeros síntomas aparecen al cabo de una semana desde la picadura, más o menos.
- Dolores musculares.
- Cansancio.
La enfermedad sigue su desarrollo y aparecen otros síntomas, a medida que son afectadas otras partes del cuerpo como:
- Taquicardia.
- Retención de líquidos.
- Anemia.
- Pérdida apreciable de peso.
Llega el momento en el que ataca al sistema nervioso central y es entonces cuando aparece la somnolencia durante el día y el insomnio durante la noche. Todo ello acompañado de una sensación de gran cansancio. Posteriormente, el enfermo cae en coma y muere.
Diagnóstico de la enfermedad del sueño
Análisis diversos
Además de una exploración visual, el médico debe recurrir a la realización de análisis de sangre para conocer el estado de salud general y poder confirmar el diagnóstico. El diagnóstico requiere tres pasos: el primero consiste en un test reactivo rápido de anticuerpos o la palpación ganglionar. El segundo paso es la punción ganglionar para extraer una muestra de tejido que se analiza al microscopio. La tercera fase del diagnóstico, confirmada la presencia del parásito en sangre, es una punción lumbar en la médula para buscar al trypanosoma en el líquido cefalorraquídeo para determinar así el estadio de la enfermedad.
Tratamiento y medicación de la enfermedad del sueño
Dos tipos de velocidades
La enfermedad del sueño es causada por dos tipos de tripanosoma que penetran en el cuerpo a través de la picadura del insecto. Uno es el ‘Trypanosoma brucei rhodesiense’ que se da en África Central y Occidental. El más frecuente es el ‘Trypanosoma brucei gambiense’, que genera una infección crónica. El enfermo puede estar infectado durante años sin saberlo, pero cuando aparecen los síntomas, la evolución es muy rápida. El rhodesiense actúa a gran velocidad y los primeros síntomas son visibles a los pocos días de haber recibido la picadura de la mosca tse-tsé.
Prevención de la enfermedad del sueño
No hay vacuna
La única prevención posible es no viajar a las zonas del África subsahariana donde vive la mosca tse-tsé, ya que no existe vacuna.